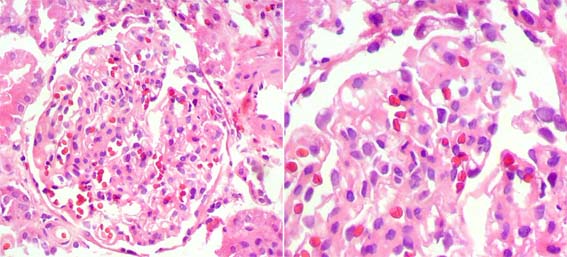

|
CASE 49 (March 2010)
Clinical information
A 29-year-old man was seen in nephrology
clinic because of edema and proteinuria. Two weeks of symptoms.
The patient reported having had 3 previous
episodes of malaria, the last one was 3 years ago; the treatment was complete
and the disease disappeared.
On physical examination: good general
condition, hydrated. Blood pressure: 120/70 mm Hg., heart rate: 71 bpm.
There are not skin lesions. Normal cardiopulmonary auscultation. Edema
in lower limbs.
Laboratory tests: blood cells count and
coagulation tests: normal. Serum creatinine: 1.5 mg/dL; BUN: 27 mg/dL;
creatinine clearance: 74.38 mL/min. Total cholesterol: 403 mg/dL; LDL:
299; triglycerides: 145. Serum total proteins: 3.9 g/dL; serum albumin:
1.3 g/dL. C3: 118 (90-180), C4: 20 (10-20), ANAs: negative; anti-DNA:
negative. Viruses B y C: negative. HIV: negative. Hemoparasites: negative.
Urinalysis: Proteins: 500 mg/dL; 2-6 leukocytes hpf; erythrocytes: 0-2
hpf; bacteria: few; nitrites: negative. Proteinuria: 9,169 mg/24h.
Renal ultrasound: Normal.
With a diagnosis of nephrotic syndrome
a renal biopsy was undertaken; on this there was only 2 glomeruli, both
normal; immunofluorescence (3 glomeruli): negative. The renal biopsy was
repeated: 14 glomeruli.
See the images.

Figure 1.
H&E, X100.

Figure 2.
Masson's trichrome stain,
X400.

Figure 3.
H&E,
X400.

Figure 4.
Methenamine-silver
stain, X400.

Figure 5.
The lesion is in the
tubular portion of the glomerular tuft. Masson's trichrome stain,
X400.
Figure 6.
In both images the same glomerulus. H&E,
X400.

Figure 7.
Direct immunofluorescence using antiserum
to IgM, X400. Only this glomerulus showed
segmental immunostaining for IgM; other 6 glomeruli
were negative.
In total, 2 of 14 glomeruli showed segmental
lesion; both near to the tubular neck.
Direct immunofluorescence for IgA, IgG, C3 and C1q: Negative.
What is your diagnosis?
See
diagnosis and discussion
[Top]
|